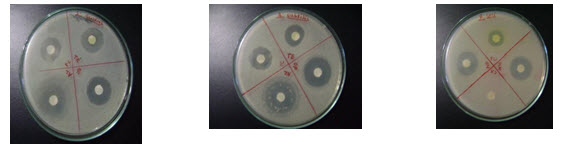

{ DOWNLOAD AS PDF }
ABOUT AUTHORS
Deepak Ku. Birla*
Shri Bherulal Pharmacy Institute
Indore, Madhya Pradesh, India
deepakbirla7@gmail.com
ABSTRACT
Momordica Charantia is the widely consumed fruit in India. The seeds, fruit, leaves, and root of the plant have been used in traditional medicine for microbial infections, sluggish digestion and intestinal gas, menstrual stimulation, wound healing, inflammation, fever reduction, hypertension and have many significant other medicinal effects. Various phytochemicals present in leaves are extracted using soxhelt apparatus with different solvents. The aim of the study is to assess the antibacterial activity and to determine the zone of inhibition of extracts on some bacterial strains. The antibacterial activity was checked against different human pathogens. The antibacterial activity was determined in the extracts using Disc diffusion method. The present study discusses antibacterial activity of Momordica Charantia extracts. Antibacterial activity was tested against (Pseudomonas aureogenosa, Staphylococcus aureus, Staphylococcus epidermis, Shigella flexineri, Bacillus substilis & E.Coli.). The results showed that the remarkable inhibition of the bacterial growth was shown against the tested organisms.
[adsense:336x280:8701650588]
REFERENCE ID: PHARMATUTOR-ART-2446
|
PharmaTutor (ISSN: 2347 - 7881) Volume 4, Issue 11 Received On: 20/06/2016; Accepted On: 02/07/2016; Published On: 01/11/2016 How to cite this article: Birla DK; Evaluation of Antibacterial activity of Momordica Charantia; PharmaTutor; 2016; 4(11); 37-40 |
INTRODUCTION
Medicinal plants are the nature’s gift to human being to make disease free healthy life. Herbal medicine is still the mainstay of about 75-80 % of the whole population, mainly in developing countries, for primary health care because, better compatibility with the human body and fewer side effects. Antibiotics are one of the most important weapons in fighting bacterial infections and have greatly benefited the health-related quality of human life since their introduction. In India, thousands of species are known to have medicinal values and the use of different parts of several medicinal plants to cure specific ailments has been in vogue since ancient times. Momordica charantia a member of the Cucurbitaceae family, is known as bitter melon, bitter gourd, balsam pear, karela, and pare. Momordica charantia has a non-nitrogenous neutral principle charantin, and on hydrolysis gives glucose and a sterol. The fruit pulp of M. charantia has soluble pectin but no free pectic acid. Galactouronic acid is also obtained from the pulp. M.charantia fruits glycosides, saponins, alkaloids, reducing sugars, resins, phenolic constituents, fixed oil and free acids1,2.
MATERIAL AND METHOD: Plant collection and preparation
Fresh leaves of M. Charantia were collected from local area of khargone district. The collected, cleaned and powdered leaves of Momordica charantia were used for the extraction purpose. 500g of powder of leaves of Momordica charantia was evenly packed in a soxhlet apparatus. It was extracted with 50% methanol. The solvent used were purified before use. The extracts were concentrated by vacuum distillation to reduce the volume 1/ 10.The concentrated extract was transferred to 100 ml beaker and the remaining solvent was evaporated on the water bath, then collected and placed in a desiccator to remove excessive moisture.
ANTIBACTERIAL SCREENING
Microorganisms used
The test organisms (Pseudomonas aureogenosa, Staphylococcus aureus, Staphylococcus epidermis, Shigella flexineri, Bacillus substilis & E.Coli.) were obtained from the Department of Research, JN Cancer Hospital and Research Center, Bhopal (M.P.).
Procedure
- All of the required apparatus and materials were sterilized in autoclave and placed in a laminar airflow cabinet under pathogen free conditions.
- Test organisms were collected from department’s microbial standard stock.
- By streaking with loop, microorganisms were inoculated in nutrient broth and incubated at 35 ºC for 12 hr.
- Nutrient agar media was prepared and poured in Petri plates and kept for drying.
- Swab (cotton) was dipped in broth having microbial growth and gently squeezed against the inside of the tube to remove excess fluid.
- Inoculated the dried surface of agar plate by streaking the swab over the entire sterile agar surface. Repeated this procedure two more times, and rotated the plate 60° each time to ensure an even distribution of inoculums.
- Replaced the plate top and allow 3 to 5 minutes, but no longer than 15 minutes, for any excess surface moisture to be absorbed before applying the test and antibiotics disks.
- Disks were dipped in drug (Momordica charantia) of different concentration (5%,10%,15%,20%, 25%, 50%, 75% & 100%) and air dried in laminar air flow before this step.
- Placed the appropriate disks (Drugs and antibiotics) evenly (no closer than 24 mm from center to center) on the surface of the agar plate by using a sterile forcep.
- Inverted the plate and placed them in an incubator at 35°C within 15 minutes after disks were applied.
- After 6-8 hrs. Of incubation, examined each plate at an interval of 2 hours and measured the diameters of the zones of complete inhibition, including the diameter of the disk.3,4,5
RESULT
The observations (Table 1) suggest that different concentration (25%, 50 %, 75 % & 100 %) were having good antibacterial activity against Streptococcus aureus, Streptococcus epidermis, Psudomonas aeriginosa, Shigella flexineri, Escherichia coli and Bacillus subtilis. Thus the extract is showing varying activity against all the microorganism.
[adsense:468x15:2204050025]
TABLE 1 : Effect of M.chrantia extract on inhibition of different bacteria.
|
S.No |
Micro organism |
Concentration (Zone of inhibition in mm) |
||||||
|
|
|
25% conc. |
50%conc. |
75%conc. |
100% conc. |
|||
|
1. |
Bacillus subtilis |
14 |
16 |
18 |
20 |
|||
|
2 |
Shigella flexineri |
13 |
15 |
18 |
19 |
|||
|
3. |
S.epidermis |
11 |
14 |
15 |
15 |
|||
|
4. |
S. aureus |
16 |
17 |
18 |
19 |
|||
|
5. |
E. coli |
14 |
16 |
19 |
21 |
|||
|
6. |
P. aureogenosa |
10 |
12 |
14 |
15 |
|||
The observations (Table 2) suggest that different concentration (5%, 10 %, 15 % & 20 %) were having antibacterial activity against Streptococcus aureus, Streptococcus epidermis, Psudomonas aeriginosa, Shigella flexineri, Escherichia coli and Bacillus subtilis. Thus the extract is showing varying activity against all the microorganism.
TABLE 2: Effect of M.chrantia extract on inhibition of different bacteria.
|
S.No |
Micro organism |
Concentration (Zone of inhibition in mm) |
|||||
|
|
|
5%conc. |
10%conc. |
15%conc. |
20%conc. |
||
|
1. |
Bacillus subtilis |
06 |
07 |
08 |
10 |
||
|
2 |
Shigella flexineri |
07 |
08 |
09 |
10 |
||
|
3. |
S.epidermis |
06 |
07 |
08 |
09 |
||
|
4. |
S. aureus |
05 |
07 |
09 |
12 |
||
|
5. |
E. coli |
09 |
10 |
11 |
13 |
||
|
6. |
P. aureogenosa |
07 |
08 |
09 |
10 |
||
Table 3: Antibacterial activity of standard antibiotic (gram positive) against different bacteria.
|
Name of microorganisms |
Name Standard antibiotics [zone of inhibition(mm)] |
|||
|
TE |
OF |
AZ |
PC |
|
|
S.aureus |
15 |
16 |
16 |
14 |
|
B.subtilis |
14 |
16 |
18 |
14 |
|
S.epidermidis |
14 |
18 |
17 |
17 |
Table 4: Antibacterial activity of standard antibiotic (gram negative) against different bacteria.
|
Name of microorganisms |
Name Standard antibiotics [zone of inhibition(mm)] |
|||
|
FU |
GM |
CX |
NF |
|
|
E.coli |
12 |
16 |
8 |
16 |
|
S.flexineri |
18 |
18 |
12 |
21 |
|
Ps. auriginosa |
14 |
13 |
18 |
20 |
Fig.1: Effect of M.chrantia extract on inhibition of different bacteria

1.Bacillus Subtilis. 2.Shigella flexinie. 3. Staphylococcus epidermis
4.Staphyloccus arusse. 5.E.coli. 6.Pseudomonas Aroginoso.
Fig. 2: Effect of M.chrantia extract on inhibition of different bacteria

Fig.1 & 2 showed Zone of inhibition of m.charantia extract in different strains of bacteria.
Fig.3: standard antibiotic against bacteria S.aureus(A), B. subtilis(B) & P. aeriginosa(C)
(A) (B) (C)
Fig.4: standard antibiotic against bacteria S. epidermidis(D) , E.COLI.(E) & S.flaxineri(F)
DISCUSSION
The initiation of microbial growth was considered as zero hour and further accordingly reading was taken. Our present study showed that antibacterial activity of 50 % methanolic extract of Momordica extract against E.coli is best in 100 % concentration after 12 hrs. The 21 mm zone of inhibition. Although 75 % concentration is having mild effect as 19 mm zone of inhibition. In Shigella floxineri 100 % concentration of extract is having good antibacterial activity at maximum zone of inhibition 19 mm. On the other hand 75 % is showing static activity from, with zone of inhibition of 18 mm. For Ps.aurigenosa 100% concentration of extract show maximum zone of inhibition 15 mm. Although the effect of 75% concentration of extract is also revealing as showing zone of inhibition 10 mm. In the case of Bacillus subtilis 75 % and 100 % concentration of extract show good activity with zone of inhibition of 18 mm and 20 mm respectively. and Streptococcus epidermis shows the inhibition 15 mm and 15 mm for 75% and 100 % concentration respectively.
CONCLUSION
The above observations suggest that different concentration (25%, 50 %, 75 % & 100 %) were having good antibacterial activity against Streptococcus aureus, Streptococcus epidermis, Psudomonas aeriginosa, Shigella flexineri, Escherichia coli and Bacillus subtilis. Thus the extract is showing varying activity against all the microorganism.
On comparing the zone of inhibition of extract to that of standard antibiotics (tobramycin, cephalexin, erythromycin & amoxicillin) extract showed better activity than tobramycin and cephalexin. But extract is not potent than erythromycin and amoxicillin in these conditions. The Momordica extract at different concentration such as 5 %, 10 %, 15 %, 20%, 25 %, 50 %, 75 % and 100 % have inhibited the bacterial zone formations in all the six strains of bacteria such as Ps.areiginosa, Sh.floxineri E.Coli, B.subtilis, S.aureus, S.epidermidis. The inhibition of bacterial zone was also observed with standard antibiotics used however it is comparativerily more than Momordica extract.
REFERENCES
1.Nadkarni AK. Nadkarni’s Indian Materia Medica, (vol. I and II), popular prakashan, Bombay,India, 1997.
2. Kirtkar KR, Basu BD, Lalit Mohan Basu. Indian medicinal plants (vols.1 and ll). 1968.
3.Cavaleiri S, Manual of antibacterial susceptibility testing, ISBN 1-55581-349-6 .
4. Reddy PS, Jamil K, Madhusudhan P. Antibacterial activity of isolates from Piper longum and Taxus baccata. Pharmaceutical Biol. 2013; 39:236–8.
5. Ahameethunisa AR and Hopper W, In vitro antibacterial activity on clinical microbial strains and antioxidant properties of Artemisia parviflora. Annals of Clinical Microbiology and Antibacterials 2012; 11:30
NOW YOU CAN ALSO PUBLISH YOUR ARTICLE ONLINE.
SUBMIT YOUR ARTICLE/PROJECT AT editor-in-chief@pharmatutor.org
Subscribe to Pharmatutor Alerts by Email
FIND OUT MORE ARTICLES AT OUR DATABASE

